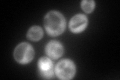
YOR276W
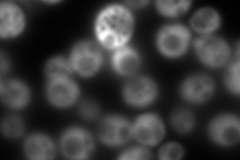
YOR276W
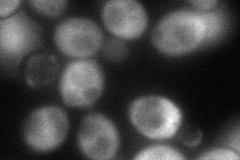
YOR276W
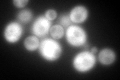
YOR276W
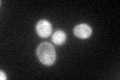
YOR276W

View description
Phosphoprotein of the mRNA cap-binding complex involved in translational control, repressor of cap-dependent translation initiation, competes with eIF4G for binding to eIF4E
Localization:
Intensity:
Fold change:
Significance:
-
C’ GFP library in SD
cytosol185.54 -
N' NOP1pr-GFP in SD

cytosol713.152 -
N' TEF2pr-mCherry in SD
cell periphery,vacuole1198.58 -
N' NATIVEpr-GFP in SD

missing0 -
N' TEF2pr-VC and Cyto-VN in SD
cytosol88.6689 -
C’ GFP library in SD+DTT
cytosol182.510.98No -
C’ GFP library in SD+H2O2

cytosol147.270.79No -
C’ GFP library in Starvation Media
cytosol144.080.77No -
C’ GFP library on the background of Pup2-DaMP

cytosol -
C’ GFP library on the background of CCT mutant

cytosol167.1930.901082No
